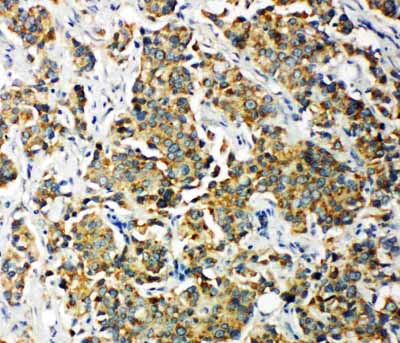
IHC - Anti-PDK2 Antibody ABO11303

Anti-PDK2 Antibody
- SPECIFICATION
- CITATIONS
- PROTOCOLS
- BACKGROUND

Application
| WB, IHC-P, ICC |
|---|---|
| Primary Accession | Q15119 |
| Host | Rabbit |
| Reactivity | Human, Mouse, Rat |
| Clonality | Polyclonal |
| Format | Lyophilized |
| Description | Rabbit IgG polyclonal antibody for [Pyruvate dehydrogenase (acetyl-transferring)] kinase isozyme 2, mitochondrial (PDK2) detection. Tested with WB, IHC-P, ICC in Human;Mouse;Rat. |
| Reconstitution | Add 0.2ml of distilled water will yield a concentration of 500ug/ml. |
| Gene ID | 5164 |
|---|---|
| Other Names | [Pyruvate dehydrogenase (acetyl-transferring)] kinase isozyme 2, mitochondrial, 2.7.11.2, Pyruvate dehydrogenase kinase isoform 2, PDH kinase 2, PDKII, PDK2, PDHK2 |
| Calculated MW | 46154 MW KDa |
| Application Details | Immunohistochemistry(Paraffin-embedded Section), 0.5-1 µg/ml, Human, Rat, Mouse, By Heat Immunocytochemistry , 0.5-1 µg/ml, Human, Mouse, Rat Western blot, 0.1-0.5 µg/ml, Human, Rat, Mouse |
| Subcellular Localization | Mitochondrion matrix. |
| Tissue Specificity | Expressed in many tissues, with the highest level in heart and skeletal muscle, intermediate levels in brain, kidney, pancreas and liver, and low levels in placenta and lung. . |
| Protein Name | [Pyruvate dehydrogenase (acetyl-transferring)] kinase isozyme 2, mitochondrial |
| Contents | Each vial contains 5mg BSA, 0.9mg NaCl, 0.2mg Na2HPO4, 0.05mg Thimerosal, 0.05mg NaN3. |
| Immunogen | A synthetic peptide corresponding to a sequence at the C-terminus of human PDK2(379-392aa WRHYQTIQEAGDWC), identical to the related rat and mouse sequences. |
| Purification | Immunogen affinity purified. |
| Cross Reactivity | No cross reactivity with other proteins |
| Storage | At -20˚C for one year. After r˚Constitution, at 4˚C for one month. It˚Can also be aliquotted and stored frozen at -20˚C for a longer time.Avoid repeated freezing and thawing. |
| Sequence Similarities | Belongs to the PDK/BCKDK protein kinase family. |
| Name | PDK2 |
|---|---|
| Synonyms | PDHK2 |
| Function | Kinase that plays a key role in the regulation of glucose and fatty acid metabolism and homeostasis via phosphorylation of the pyruvate dehydrogenase subunits PDHA1 and PDHA2. This inhibits pyruvate dehydrogenase activity, and thereby regulates metabolite flux through the tricarboxylic acid cycle, down-regulates aerobic respiration and inhibits the formation of acetyl-coenzyme A from pyruvate. Inhibition of pyruvate dehydrogenase decreases glucose utilization and increases fat metabolism. Mediates cellular responses to insulin. Plays an important role in maintaining normal blood glucose levels and in metabolic adaptation to nutrient availability. Via its regulation of pyruvate dehydrogenase activity, plays an important role in maintaining normal blood pH and in preventing the accumulation of ketone bodies under starvation. Plays a role in the regulation of cell proliferation and in resistance to apoptosis under oxidative stress. Plays a role in p53/TP53-mediated apoptosis. |
| Cellular Location | Mitochondrion matrix. |
| Tissue Location | Expressed in many tissues, with the highest level in heart and skeletal muscle, intermediate levels in brain, kidney, pancreas and liver, and low levels in placenta and lung |

Thousands of laboratories across the world have published research that depended on the performance of antibodies from Abcepta to advance their research. Check out links to articles that cite our products in major peer-reviewed journals, organized by research category.
info@abcepta.com, and receive a free "I Love Antibodies" mug.
Provided below are standard protocols that you may find useful for product applications.
Background
PDK2 (Pyruvate Dehydrogenase Kinase Isoenzyme 2), is an enzyme that in humans is encoded by the PDK2 gene. This gene encodes a member of the pyruvate dehydrogenase kinase family. The encoded protein phosphorylates pyruvate dehydrogenase, down-regulating the activity of the mitochondrial pyruvate dehydrogenase complex. Overexpression of this gene may play a role in both cancer and diabetes. Alternatively spliced transcript variants encoding multiple isoforms have been observed for this gene.
If you have used an Abcepta product and would like to share how it has performed, please click on the "Submit Review" button and provide the requested information. Our staff will examine and post your review and contact you if needed.
If you have any additional inquiries please email technical services at tech@abcepta.com.





Foundational characteristics of cancer include proliferation, angiogenesis, migration, evasion of apoptosis, and cellular immortality. Find key markers for these cellular processes and antibodies to detect them.
The SUMOplot™ Analysis Program predicts and scores sumoylation sites in your protein. SUMOylation is a post-translational modification involved in various cellular processes, such as nuclear-cytosolic transport, transcriptional regulation, apoptosis, protein stability, response to stress, and progression through the cell cycle.
The Autophagy Receptor Motif Plotter predicts and scores autophagy receptor binding sites in your protein. Identifying proteins connected to this pathway is critical to understanding the role of autophagy in physiological as well as pathological processes such as development, differentiation, neurodegenerative diseases, stress, infection, and cancer.